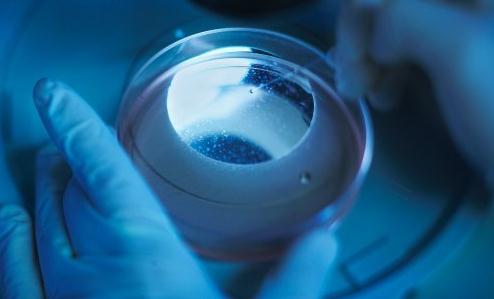

-
700多人成功戒烟100天
2016/11/012016健康北京戒烟大赛目前进入戒烟成果验收和总结阶段。戒烟大赛组委会10月11日通过12320热线平台给所有参赛者发送短信,提醒成功戒烟100天的参赛者回复短信以参加下一阶段活......
-
日本烟草9月国内卷烟销量同比下滑5.4%
2016/10/24根据日本烟草公司公布的初步数据显示,9月份,该公司的国内卷烟销量为87亿支,比去年同期下滑5.4%。2015年9月的国内卷烟销量比2014年同期下滑1.9%。 ...
-
国税总局就烟叶税法公开征求意见
2016/10/24国家税务总局就《中华人民共和国烟叶税法》公开征求意见,征求意见稿修改了价外补贴统一按收购价款的10%计算的现行规定,改为由省级人民政府根据本地区纳税人给予烟叶生产销......
-
吸烟将对基因产生长久影响
2016/10/24美国国家环境健康科学研究所发表于美国心脏协会旗下学术期刊《循环:心血管遗传学》的一项研究显示,吸烟者DNA甲基化的印记,在戒烟后也可保留30年以上,使罹患癌症、骨质......
-
烟草烟雾引发癌症再添新证据
2016/10/24近日,刊登在国际杂志PLoS ONE上的一项研究报告中,来自肯塔基大学的研究人员通过研究阐明了一种新方法,即烟草烟雾能够促进肺癌的发生,研究者发现,烟草烟雾或许能够......
-
上海三大火车站拟10月25日起室内全面禁烟
2016/10/24据上海发布,为了给广大旅客提供一个无烟的良好出行环境,自10月25日起,上海站、上海虹桥站、上海南站室内吸烟室将全部撤除,站内也不会摆放任何形式的吸烟器具。根据相关法......
-
严格控烟,能不能做到?
2016/10/24一直以来就有一种“严格的控烟太难,不可能完全做到的,开一些口子很正常”的论调存在。对此,上海、北京、深圳、广州等多地的控烟行政执法部门负责人表示,一定要在在室内公......
-
北京控烟16个月 575家单位被罚款158万元
2016/10/1810月12日,北京市卫生监督所副所长王本进披露,北京市控烟执法16个月(2015.06.01—2016.09.30)以来,全市共出动卫生监督执法人员219594人次,共监督检查109302户次,发现不......